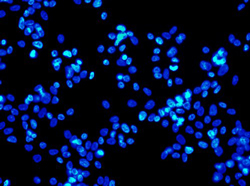

Les applications biomédicales de recherche et de diagnostics requièrent généralement des imageurs dotés d’une résolution spatiale élevée, d’une reproduction précise des couleurs, d’une grande sensibilité dans des conditions de faible luminosité, et, dans certains cas, d’une combinaison de ces trois facteurs pour améliorer la fiabilité des données. Il est indispensable de disposer d’une caméra pour microscope, d’une caméra pour histologie, d’une caméra pour cytologie/cytogénétique, d’une caméra pour épifluorescence appropriées pour établir un diagnostic précis dans une application clinique ou de données fiables à des fins de recherche. Comment déterminer quelle caméra de vision artificielle est la plus adaptée à votre application ? Dans les sections suivantes, nous couvrons plusieurs aspects à prendre en compte au moment de choisir une caméra de vision artificielle pour vos applications biomédicales et des sciences de la vie.
Les applications biomédicales de recherche et de diagnostics requièrent généralement des imageurs dotés d’une résolution spatiale élevée, d’une reproduction précise des couleurs, d’une grande sensibilité dans des conditions de faible luminosité, et, dans certains cas, d’une combinaison de ces trois facteurs pour améliorer la fiabilité des données. Il est indispensable de disposer d’une caméra pour microscope, d’une caméra pour histologie, d’une caméra pour cytologie/cytogénétique, d’une caméra pour épifluorescence appropriées pour établir un diagnostic précis dans une application clinique ou de données fiables à des fins de recherche. Comment déterminer quelle caméra de vision artificielle est la plus adaptée à votre application ? Dans les sections suivantes, nous couvrons plusieurs aspects à prendre en compte au moment de choisir une caméra de vision artificielle pour vos applications biomédicales et des sciences de la vie.
Facteurs propres à l’application à prendre en compte :
La résolution requise dépend du grossissement de la structure d’intérêt dans l’échantillonnage relatif à la taille des pixels sur la caméra ; c’est-à-dire que la haute résolution dans une application pour la microscopie peut être atteinte par une caméra 2MP, une caméra 25MP, ou entre les deux. Elle dépend du grossissement de la structure d’intérêt dans l’échantillonnage par les éléments optiques relatif à la taille des pixels sur la caméra. Pour sélectionner les meilleures options de la caméra et obtenir la résolution souhaitée, commencez par déterminer la taille de la plus petite structure dans l’échantillonnage que vous souhaitez identifier. Multipliez-la ensuite par les grossissements de l’objectif dans votre système optique. Vous obtiendrez ainsi la taille de ces structures lors de leur projection sur le capteur de la caméra.
Si la taille de la structure correspond à au moins 2,33 (Nyquist) fois la taille d’un pixel sur la capteur de la caméra, la caméra doit alors pouvoir déterminer cette structure. Par exemple, si la taille des ces structures projetées est d’environ 8 um, une caméra de 3,45 um pixels doit être capable de déterminer ces structures. D’autres méthodes existent pour mesurer la résolution (par ex. les paires de lignes) mais il s’agit là d’un calcul facile pour trouver les options de la caméra adaptées au test.
Les applications d’imagerie comme l’histologie, la cytologie et la cytogénétique fonctionnent avec un large éventail de lumières blanches (entre 400 nm et 700 nm) ou utilisent une longueur d’onde sélectionnée dans cette plage (par exemple, 565 nm). Si les spécimens dans ces échantillonnages ne sont pas vivants (ou fixes), ils peuvent être exposés à des niveaux de lumière vive sans risque de disparition de la tache ou de destruction de l’échantillonnage. Dans ces conditions, l’exigence principale de la caméra est la haute résolution et la reproduction des couleurs. En d’autres termes, la sensibilité basse lumière n’est pas un facteur important. Pour identifier les modèles haute résolution, utilisez notre sélecteur de caméras de vision artificielle FLIR et effectuez un filtre et un tri par mégapixels.
Pour les applications d’imagerie avec spécimens vivants, le défi consiste à éviter la surexposition de l’échantillonnage à une luminosité trop élevée, ce qui blanchirait les molécules fluorescentes ou détruirait le spécimen. Ces applications utilisent généralement une technique appelée épifluorescence. Les techniques d’épifluorescence peuvent être utilisées sur des spécimens fixes et vivants. Certains spécimens sont rares ou onéreux et le processus de création d’échantillonnages peut s’avérer coûteux en termes de matériaux et de main-d’œuvre. Par conséquent, un système qui préserve la qualité des échantillonnages peut permettre de réduire les coûts de ces applications d’imagerie.
L’épifluorescence utilise une longueur d’onde à énergie élevée filtrée pour exciter l’échantillonnage à émettre une longueur d’onde à faible énergie. La longueur d’onde à faible énergie est filtrée jusqu’à la caméra. Dans ces conditions, l’exigence principale est la sensibilité car il est possible d’utiliser une lumière moins intense et moins dommageable sur l’échantillonnage. Une caméra dotée d’une excellente sensibilité peut fournir des images de grande qualité même lorsque la lumière émise est de faible énergie.
Pour identifier les modèles dotés d’une excellente sensibilité dans des conditions de faible luminosité, vous pouvez vous concentrer sur trois caractéristiques : la sensibilité absolue, l’efficacité quantique et la plage dynamique. La sensibilité absolue est le nombre de photons nécessaires pour obtenir un signal équivalent au bruit observé par le capteur. Plus le nombre est bas, meilleur est le résultat. L’efficacité quantique est le pourcentage de photons convertis en électrons à une longueur d’onde spécifique. Ici, un nombre élevé est préférable. La plage dynamique est le rapport du signal sur bruit, y compris le bruit sombre temporel (le bruit dans le capteur lorsqu’aucun signal n’existe). Ici, un nombre élevé est préférable. Pour faciliter la comparaison, utilisez le sélecteur de modèles FLIR pour filtrer et identifier les valeurs les plus élevées.
En général, les modèles monochromes ont de meilleures performances dans des conditions de faible éclairage par rapport à leurs équivalents en couleurs. Pour connaître les détails de la performance d’imagerie d’un modèle, consultez le document Performance de l’imagerie EMVA pour le modèle.
 Pour les applications qui utilisent à la fois la lumière blanche et l’épifluorescence, recherchez des modèles qui offrent la nouvelle caractéristique de gain de conversion de Sony qui permet d’optimiser le capteur pour une capacité de sensibilité élevée ou de saturation élevée. Un gain de conversion élevé convient parfaitement dans les environnements à faible luminosité, car le bruit de lecture est réduit, créant ainsi un seuil de faible sensibilité absolue idéal pour détecter les signaux faibles avec des temps d’exposition courts. Le gain de conversion faible est quant à lui parfait dans des conditions très lumineuses, car la capacité de saturation est maximisée, améliorant ainsi la plage dynamique. La plage dynamique maximale sera limitée par le convertisseur analogique-numérique 12 bits.
Pour les applications qui utilisent à la fois la lumière blanche et l’épifluorescence, recherchez des modèles qui offrent la nouvelle caractéristique de gain de conversion de Sony qui permet d’optimiser le capteur pour une capacité de sensibilité élevée ou de saturation élevée. Un gain de conversion élevé convient parfaitement dans les environnements à faible luminosité, car le bruit de lecture est réduit, créant ainsi un seuil de faible sensibilité absolue idéal pour détecter les signaux faibles avec des temps d’exposition courts. Le gain de conversion faible est quant à lui parfait dans des conditions très lumineuses, car la capacité de saturation est maximisée, améliorant ainsi la plage dynamique. La plage dynamique maximale sera limitée par le convertisseur analogique-numérique 12 bits.
Pour consulter la liste des modèles avec gain de conversion, reportez-vous à notre Évaluation des capteurs de vision artificielle. Pour vous aider à choisir les caméras appropriées pour votre application, contactez l’un de nos experts en vision artificielle.
 Lorsque vous choisissez une caméra, opter pour un nouveau capteur CMOS est toujours un bon point de départ. Les nouveaux capteurs offrent généralement de bonnes performances (et peuvent s’avérer moins chers). En outre, si l’application en question nécessite l’achat de plusieurs caméras sur plusieurs années (par exemple, la fabrication d’un instrument de diagnostic), il est alors essentiel de choisir une caméra qui n’ait pas atteint la fin de son cycle de vie. Vous devrez sinon assumer le coût de la conception d’une caméra de remplacement de manière prématurée.
Lorsque vous choisissez une caméra, opter pour un nouveau capteur CMOS est toujours un bon point de départ. Les nouveaux capteurs offrent généralement de bonnes performances (et peuvent s’avérer moins chers). En outre, si l’application en question nécessite l’achat de plusieurs caméras sur plusieurs années (par exemple, la fabrication d’un instrument de diagnostic), il est alors essentiel de choisir une caméra qui n’ait pas atteint la fin de son cycle de vie. Vous devrez sinon assumer le coût de la conception d’une caméra de remplacement de manière prématurée.
FLIR fabrique plus de 200 variantes de caméras de vision artificielle qui entrent généralement dans trois familles de caméras qui utilisent les derniers capteurs CMOS : Blackfly S, Oryx et Firefly.
La famille de caméras Blackfly S offre la plus large gamme de capteurs, de facteurs de forme et d’interfaces. Grâce à chaque modèle offert dans les variantes USB3 et GigE, ces caméras sont extrêmement polyvalentes et faciles à intégrer lors de la phase de conception. Les versions Blackfly S de niveau carte sont des versions miniaturisées de notre gamme riche en fonctionnalités et sont particulièrement adaptées aux applications embarquées à contrainte d’espace. La large gamme de fonctions, un bon rapport qualité-prix, et les résolutions allant jusqu’à 24MP, font d’elles un choix idéal dans les applications biomédicales et des sciences de la vie.
La famille de caméras Oryx offre des capteurs haute résolution couplés à l’interface rapide 10GigE, permettant ainsi la capture d’images haute résolution 4K, 12 bits à plus de 60 images par seconde. L’interface 10GBASE-T d’Oryx est une norme éprouvée et largement déployée qui permet un transfert d’image fiable pour des longueurs de câble supérieures à 50 mètres sur un CAT6A peu coûteux ou supérieure à 30 m sur un CAT5e.
La famille de caméras Firefly offre un très faible encombrement, une conception légère, une faible consommation d’énergie et un prix accessible. Le modèle Firefly DL offre également la possibilité d’exécuter un réseau neuronal précédemment entraîné qui peut être utilisé pour la détection ou la classification d’objets.
Toutes les caméras couleur de vision artificielle FLIR offrent la possibilité de personnaliser la reproduction des couleurs sous la forme de différentes options d’équilibrage des blancs, et d’utiliser une matrice unique de correction des couleurs, ce qui est important dans l’imagerie biomédicale où la précision des couleurs peut varier selon l’analyse visuelle humaine pour le diagnostic ou un format lisible par une machine pour la précision des données. Pour plus d’informations sur ces fonctions, consultez la section Utilisation de l’équilibrage des blancs avec Blackfly S et Spinnaker et Utilisation de la correction des couleurs dans Blackfly S et Oryx.
En outre, les familles de caméras Blackfly S, Oryx et Firefly de vision artificielle FLIR peuvent être controlées et programmées à l’aide de GenICam3 et du Spinnaker SDK, conçu en fonction de sa facilité de développement et de déploiement, de façon à nous permettre d’accélérer le développement et le test de l’application.